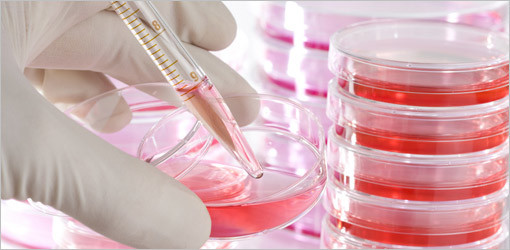
Lactobacillus Reuteri Prodentis wirksam bei der Behandlung von Parodontose

Wissenschaft und Forschung 21.02.2011
Lactobacillus Reuteri Prodentis wirksam bei der Behandlung von Parodontose
Eine aktuelle Studie belegt, dass sich L. Reuteri Prodentis bei der Standardbehandlung (professionelle Zahnreinigung) synergistisch verhalten und somit die untersuchte Taschentiefe (probing pocket depth, PPD) sowie das klinische Attachmentniveau (clinical attachment level, CAL), die zwei wichtigsten Parameter bei der Beurteilung der Schwere von Parodontose, erheblich reduzieren.
Desweiteren erzeugt L. Reuteri Prodentis - als erstes Probiotikum überhaupt - erhebliche Verringerungen von drei Krankheitserregern bei Patienten mit chronischer Parodontose. Die Studie bestätigt ausserdem die entzündungshemmende Wirkung von L. Reuteri Prodentis bei Zahnfleischentzündungen (Gingivitis).
Chronische Parodontose betrifft bis zu 40% der erwachsenen Bevölkerung. Die Standardbehandlung hat die Beseitigung des Zahnbelags in den Zahnfleischtaschen zum Ziel, um die parodontal-pathogenen Keime zu reduzieren und somit das Fortschreiten der Krankheit zu verhindern.
Dreissig an chronischer Parodontose leidenden Patienten wurden in die doppelblinden, randomisierten, Placebo-kontrollierten klinischen Versuche einbezogen, die 42 Tage andauerten. Am Tag 0 wurden die Zähne in der einen Hälfte des Mundes mit SRP behandelt, während die Zähne auf der anderen Seite unbehandelt blieben. Von Tag 21 bis 42 wurde den Patienten zusätzlich entweder L. Reuteri Prodentis Rauten (1X108 CFU DSM 17938 und 1x108 CFU ATCC PTA 5289) oder Placebo-Rauten zweimal täglich verabreicht.
Das Ergebnis zeigte, dass eine Kombination aus L. Reuteri Prodentis und SRP deutlich bessere Ergebnisse erzielte als alle anderen Methoden zur Verringerung von Gingivitis und Zahnbelag. Darüber hinaus verringert L. Reuteri Prodentis, entweder für sich genommen oder infolge einer SRP, erheblich die pathogenen Aggregibacter Actinomycetemcomitans, Porphyromonas Gingivalis und Prevotella Intermedia um bis zu 90% im Vergleich zu Behandlungsmethoden ohne L. Reuteri Prodentis. Ebenso erwies sich die Kombination aus L. Reuteri Prodentis und SPR als erheblich besser zur Reduktion von sowohl PPD (p<0.001) und CAL (p<0.001) als SPR allein (siehe Anhang).
- Diese kurzfristige Studie belegt, dass L. Reuteri Prodentis per se eine starke Wirkung auf die Krankheitserreger der Parodontose hat und eine Kombination aus L. Reuteri Prodentis und SRP sowohl PPD als auch CAL synergistisch verbessern, so Professor Vandana vom College of Dental Science in Davangere, Indien.
- Die Ergebnisse stärken die Rolle von L. Reuteri Prodentis als bewährte Behandlungsmethode für Patienten mit Parodontose, so Peter Rothschild, Präsident von BioGaia AB.
Die Studienergebnisse wurden am 2. November 2010 online im "Journal of Oral Microbiology" veröffentlicht, doi: 10.3402/jom.v2i0.5344. Auf die Studie kann hier zugegriffen werden.
Quelle: BioGaia